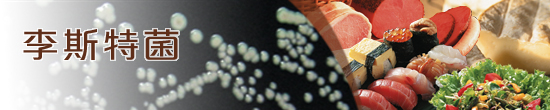

期刋及刊物
食物安全專頁
食物安全焦點
- 高危人士感染李斯特菌的風險 (二零二二年十月第一百九十五期)
- 金菇與李斯特菌 (二零二零年四月第一百六十五期)
- 冷藏蔬菜含李斯特菌引發疫情 (二零一八年八月第一百四十五期)
- 哈密瓜(又稱皺皮瓜)與李斯特菌 (二零一八年四月第一百四十一期)
- 帶食物探病?小心李斯特菌! (二零一五年十二月第一百一十三期)
- 冷熏三文魚與李斯特菌 (二零一五年五月第一百零六期)
- 丹麥腸含李斯特菌 (二零一四年九月第九十八期)
- 乳酪(芝士)製品中的李斯特菌 (二零一四年五月第九十四期)
- 李斯特菌病與懷孕 (二零一二年十月第七十五期)
- 皺皮瓜中的李斯特菌 (二零一一年十一月第六十四期)
- 雞尾腸中的李斯特菌 (二零一零年五月第四十六期)
- 李斯特菌與青口 (二零零七年十二月第十七期)
- 李斯特菌及其規控 (二零零七年七月第十二期)
- 食物中的李斯特菌 (二零零七年三月第八期)
- 李斯特菌與高危人士 (二零零七年二月第七期)
單張
風險評估研究
- 保質期長的預先包裝冷藏食品的微生物質素(二零一四年九月)